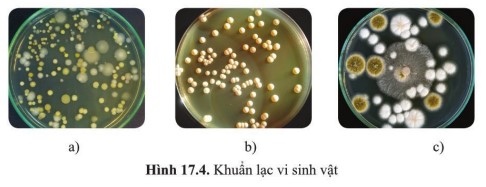
Em hãy cho biết khuẩn lạc vi khuẩn, nấm mốc và nấm men tương ứng

Hướng dẫn giải luyện tập 3 trang 104 SGK Sinh 10 thuộc Bài 17: Vi sinh vật và các phương pháp nghiên cứu vi sinh vật - Sinh học lớp 10 Cánh diều.
Câu hỏi
Em hãy cho biết khuẩn lạc vi khuẩn, nấm mốc và nấm men tương ứng với ảnh nào trong các ảnh ở hình 17.4.
Trả lời
Hình a - Khuẩn lạc vi khuẩn vì các khuẩn lạc vi khuẩn thường nhầy ướt, bề mặt thường dẹt và có nhiều màu sắc.
Hình b - Khuẩn lạc nấm men vì khuẩn lạc nấm men thường khô, tròn đều và lồi ở tâm, thường có màu trắng sữa.
Hình c - Khuẩn lạc nấm mốc vì khuẩn lạc nấm mốc thường lan rộng, có nhiều màu sắc khác nhau như trắng, vàng, đen, xanh,…
-/-
Trên đây là hướng dẫn luyện tập 3 trang 104 SGK Sinh 10 Cánh diều :"Em hãy cho biết khuẩn lạc vi khuẩn, nấm mốc và nấm men tương ứng với ảnh nào trong các ảnh ở hình 17.4.". Đừng quên tham khảo thêm các câu hỏi trong trọn bộ Giải sinh 10 Cánh diều mà chúng tôi đã tổng hợp.
